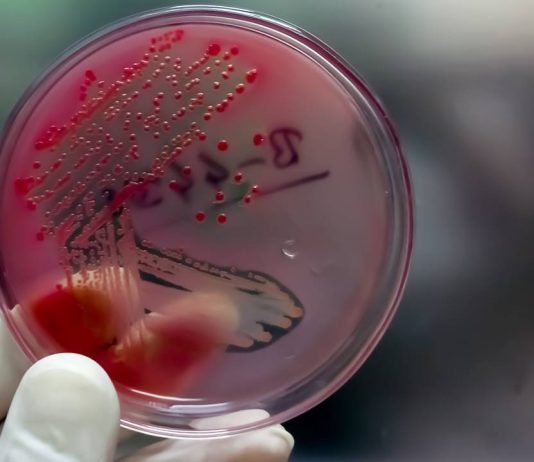
Sexually transmitted diseases that are increasing: gonorrhea, syphilis, monkeypox Sexually transmitted diseases that are increasing gonorrhea, syphilis, monkeypox

Stress and anxiety can trigger skin irritation with typical symptoms of dermatitis. We explain how to relieve it with natural solutions.
Stress dermatitis: what it is and why it occurs
Stress dermatitis: symptoms
Natural remedies for stress dermatitis
Daily responsibilities, work, family commitments, traumatic situations... They are factors that can cause stress to which we are...
The use of birth control pills can lead to some side effects, such as an increased chance of cardiovascular disease. We explain what the risks are.
What types of birth control pills are there and how do they work?
Birth control pills and risk of cardiovascular disease
Birth control pills and skin...
Sexually transmitted diseases that are increasing: gonorrhea, syphilis, monkeypox
HealthyExclusive - 0
Sexually transmitted infections continue to increase, especially among young people. We explain what are the modes of contagion and the symptoms of three of those that have increased the most: gonorrhea, syphilis and monkeypox.
Gonorrhea: what it is and what its symptoms are
Syphilis: what it is and what its symptoms...
Certain colors encourage tranquility and relaxation, thus facilitating rest; while others can make it harder to fall asleep.
Warm, light or cool colors for the bedroom?
Soothing colors for adult bedrooms
The atmosphere of the room where we sleep is key to our rest: temperature, humidity, lighting, comfort ... and also the colors. The right...
Going out to the mountains tones the body, strengthens the muscles and eliminates toxins. Walking through it now provides the well-being and health necessary to face the coming months. Find out how to organize the excursion to the mountain to get the most out of it.
The contact with the...
Pain in the knees is very common and can become disabling. We explain why it happens and what is the best thing you can do to take care of your knees.
Causes of knee pain when walking
Causes of resting knee pain
How to care for your knees
Knee pain is very common, since...